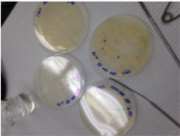

Uploads by Brittney Thompson
From OpenWetWare
Jump to navigationJump to search
This special page shows all uploaded files.
| Date | Name | Thumbnail | Size | Description |
|---|---|---|---|---|
| 00:33, 11 March 2015 | EstrogenTable.png (file) |  |
139 KB | |
| 00:33, 11 March 2015 | Day7Fixedslides.png (file) | 32 KB | ||
| 00:33, 11 March 2015 | ControlTable.png (file) |  |
139 KB | |
| 19:57, 27 February 2015 | Electro13.JPG (file) |  |
28 KB | |
| 19:35, 27 February 2015 | Foodweb1313.png (file) |  |
154 KB | |
| 19:34, 27 February 2015 | FoodWeb13.png (file) |  |
160 KB | |
| 19:24, 27 February 2015 | PlantTable13.png (file) |  |
164 KB | |
| 19:21, 27 February 2015 | Flowerbundle13.JPG (file) |  |
3.72 MB | |
| 19:20, 27 February 2015 | Cattail13.JPG (file) |  |
3.47 MB | |
| 19:14, 27 February 2015 | Slenderleaf13.JPG (file) |  |
42 KB | |
| 19:14, 27 February 2015 | Moss13.JPG (file) |  |
4.28 MB | |
| 19:13, 27 February 2015 | Hay13.JPG (file) |  |
45 KB | |
| 19:05, 27 February 2015 | Gramstain13.png (file) |  |
212 KB | |
| 19:05, 27 February 2015 | Agarplatestet13.png (file) |  |
138 KB | |
| 19:04, 27 February 2015 | Agarplates13.png (file) | |
141 KB | |
| 18:46, 27 February 2015 | Pandorina13.png (file) |  |
23 KB | |
| 18:46, 27 February 2015 | Paramecium1313.png (file) |  |
26 KB | |
| 18:46, 27 February 2015 | Blepharisma13.png (file) |  |
23 KB | |
| 18:41, 27 February 2015 | Paramecium13.png (file) |  |
23 KB | |
| 18:40, 27 February 2015 | Copidium13.png (file) |  |
27 KB | |
| 18:40, 27 February 2015 | Amoeba13.png (file) |  |
37 KB | |
| 04:07, 24 February 2015 | TableofInvertebrates.jpg (file) |  |
102 KB | |
| 21:22, 22 February 2015 | MarshFlowerBundle.JPG (file) |  |
3.72 MB | |
| 21:22, 22 February 2015 | MarshPlant1.JPG (file) |  |
3.47 MB | |
| 21:21, 22 February 2015 | ElectrophoresisMarsh.JPG (file) |  |
28 KB | |
| 21:20, 22 February 2015 | Serial Dilution Table.png (file) |  |
59 KB | |
| 21:20, 22 February 2015 | Bacteria Characterization.jpg (file) | 225 KB | ||
| 21:19, 22 February 2015 | Marsh.jpg (file) |  |
59 KB | |
| 03:15, 27 January 2015 | Marsh.png (file) |  |
215 KB |